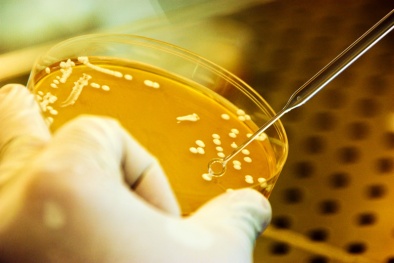
Chất lượng Việt Nam kiểm nghiệm thực phẩm trên thị trường tìm 'độc'

SỰ KIỆN: CHÀO MỪNG NGÀY THÀNH LẬP NGÀNH TIÊU CHUẨN ĐO LƯỜNG CHẤT LƯỢNG

Đẩy mạnh hoạt động hướng tới bầu cử đại biểu Quốc hội và hội đồng nhân dân các cấp
(VietQ.vn) - Bộ Khoa học và Công nghệ, Tổng cục Tiêu chuẩn Đo lường Chất lượng và các đơn vị trong ngành tổ chức chuỗi các hoạt động hướng tới bầu cử đại biểu Quốc hội khóa XIV và Hội đồng nhân dân các cấp nhiệm kỳ 2016-2021.

Hướng tới bầu cử đại biểu Quốc hội khóa XIV và đại biểu Hội đồng nhân dân các cấp nhiệm kì 2016-2021
(VietQ.vn) - Bộ Khoa học và Công nghệ, Tổng cục Tiêu chuẩn Đo lường Chất lượng và các đơn vị trực thuộc, đẩy mạnh các hoạt động hướng tới bầu cử đại biểu Quốc hội khóa XIV và đại biểu Hội đồng nhân dân các cấp nhiệm kì 2016-2021. Dưới đây là toàn văn Luật bầu cử đại biểu Quốc hội và đại biểu Hội đồng nhân dân (Luật số: 85/2015/QH13)

Khai trương Trung tâm Đổi mới Công nghệ Việt Nam – Hàn Quốc
(VietQ.vn) - Sáng nay (26/4), Việt Nam khai trương Trung tâm Đổi mới Công nghệ Việt – Hàn về Tiêu chuẩn Đo lường Chất lượng.

Hợp tác bồi dưỡng nghiệp vụ thanh tra tiêu chuẩn đo lường chất lượng
(VietQ.vn) - Tổng cục Tiêu chuẩn Đo lường Chất lượng (TCĐLCL) phối hợp với Trường Cán bộ Thanh tra tổ chức bồi dưỡng nghiệp vụ thanh tra chuyên ngành TCĐLCL.

Tập đoàn IKEA tìm hiểu về tiêu chuẩn đo lường chất lượng ở Việt Nam
(VietQ.vn) - Tập đoàn IKEA mong muốn tìm hiểu các quy định về tiêu chuẩn đo lường chất lượng để thúc đẩy đầu tư vào Việt Nam.

Nghị định mới về chất lượng sản phẩm, hàng hóa vật liệu xây dựng
(VietQ.vn) - Nghị định về quản lý vật liệu xây dựng đã được Chính phủ ban hành, trong đó yêu cầu về chất lượng sản phẩm, hàng hóa vật liệu xây dựng.

Chuyên gia lý giải về tác hại của xăng pha chế từ xăng máy bay
(VietQ.vn) - Chuyên gia hóa dầu khẳng định, phương tiện giao thông sử dụng xăng pha chế từ xăng máy bay có thể nguy hại đến tài sản, thậm chí cả tính mạng.

Tổng cục TCĐLCL nói gì về 8.815 lít chất lỏng nghi là xăng máy bay tuồn ra thị trường?
(VietQ.vn) - BCĐ 389 Quốc gia nhận định, vụ 'tuồn" xăng máy bay bán ra ngoài thị trường là rất nghiêm trọng, cần phải làm rõ nguồn gốc xuất xứ của lô hàng này.

Giải thưởng Chất lượng Quốc gia: Tôn vinh những đỉnh cao năng suất chất lượng
(VietQ.vn) - Giải thưởng Chất lượng Quốc gia tôn vinh các doanh nghiệp xuất sắc nhất về năng suất chất lượng; mở ra triển vọng cho doanh nghiệp phát triển bền vững.

Giải thưởng Chất lượng Quốc Gia: Bệ phóng cho doanh nghiệp tới tương lai
(VietQ.vn) - Giải thưởng Chất lượng Quốc gia với 7 tiêu chí khắt khe, chính là bước hoàn thiện của doanh nghiệp, hướng tới hội nhập và phát triển.

STAMEQ đồng hành cùng doanh nghiệp vượt qua rào cản kỹ thuật khi xuất khẩu
(VietQ.vn) - STAMEQ sẽ luôn đồng hành cùng doanh nghiệp vượt qua các rào cản kỹ thuật trong quá trình mở rộng thị trường xuất khẩu.

Dệt may Việt Nam đứng thứ 5 xuất khẩu vào thị trường Hoa Kỳ
(VietQ.vn) - Dệt may là mặt hàng xuất khẩu trọng điểm sang thị trường Hoa Kỳ, đó là thông tin được CPSC công bố tại buổi làm việc với Tổng cục TCĐLCL chiều ngày 7/3.

Việt Nam-Hàn Quốc thúc đẩy hợp tác về Tiêu chuẩn Đo lường Chất lượng
(VietQ.vn) - Để tăng cường sự hợp tác giữa Việt Nam - Hàn Quốc, Lễ ký kết Biên bản Hợp tác giữa Tổng cục TCĐLCL và KOTRA đã được diễn ra sáng nay tại Hà Nội.

Tập huấn quản lý đo lường chất lượng trong kinh doanh xăng dầu cho Tập đoàn Petrolimex
(VietQ.vn) - Tổng cụcTCĐLCL vừa tập huấn nghiệp vụ về quản lý đo lường chất lượng trong kinh doanh xăng dầu cho doanh nghiệp Tập đoàn Petrolimex khu vực phía Bắc.
Chất lượng Việt Nam kiểm nghiệm thực phẩm trên thị trường tìm 'độc'
(VietQ.vn) - Với nhu cầu của bạn đọc và an toàn sức khỏe của người tiêu dùng, vừa qua Chất lượng Việt Nam đã cùng với cơ quan chức năng lấy mẫu thực phẩm trên thị trường, kiểm nghiệm tìm "độc".














